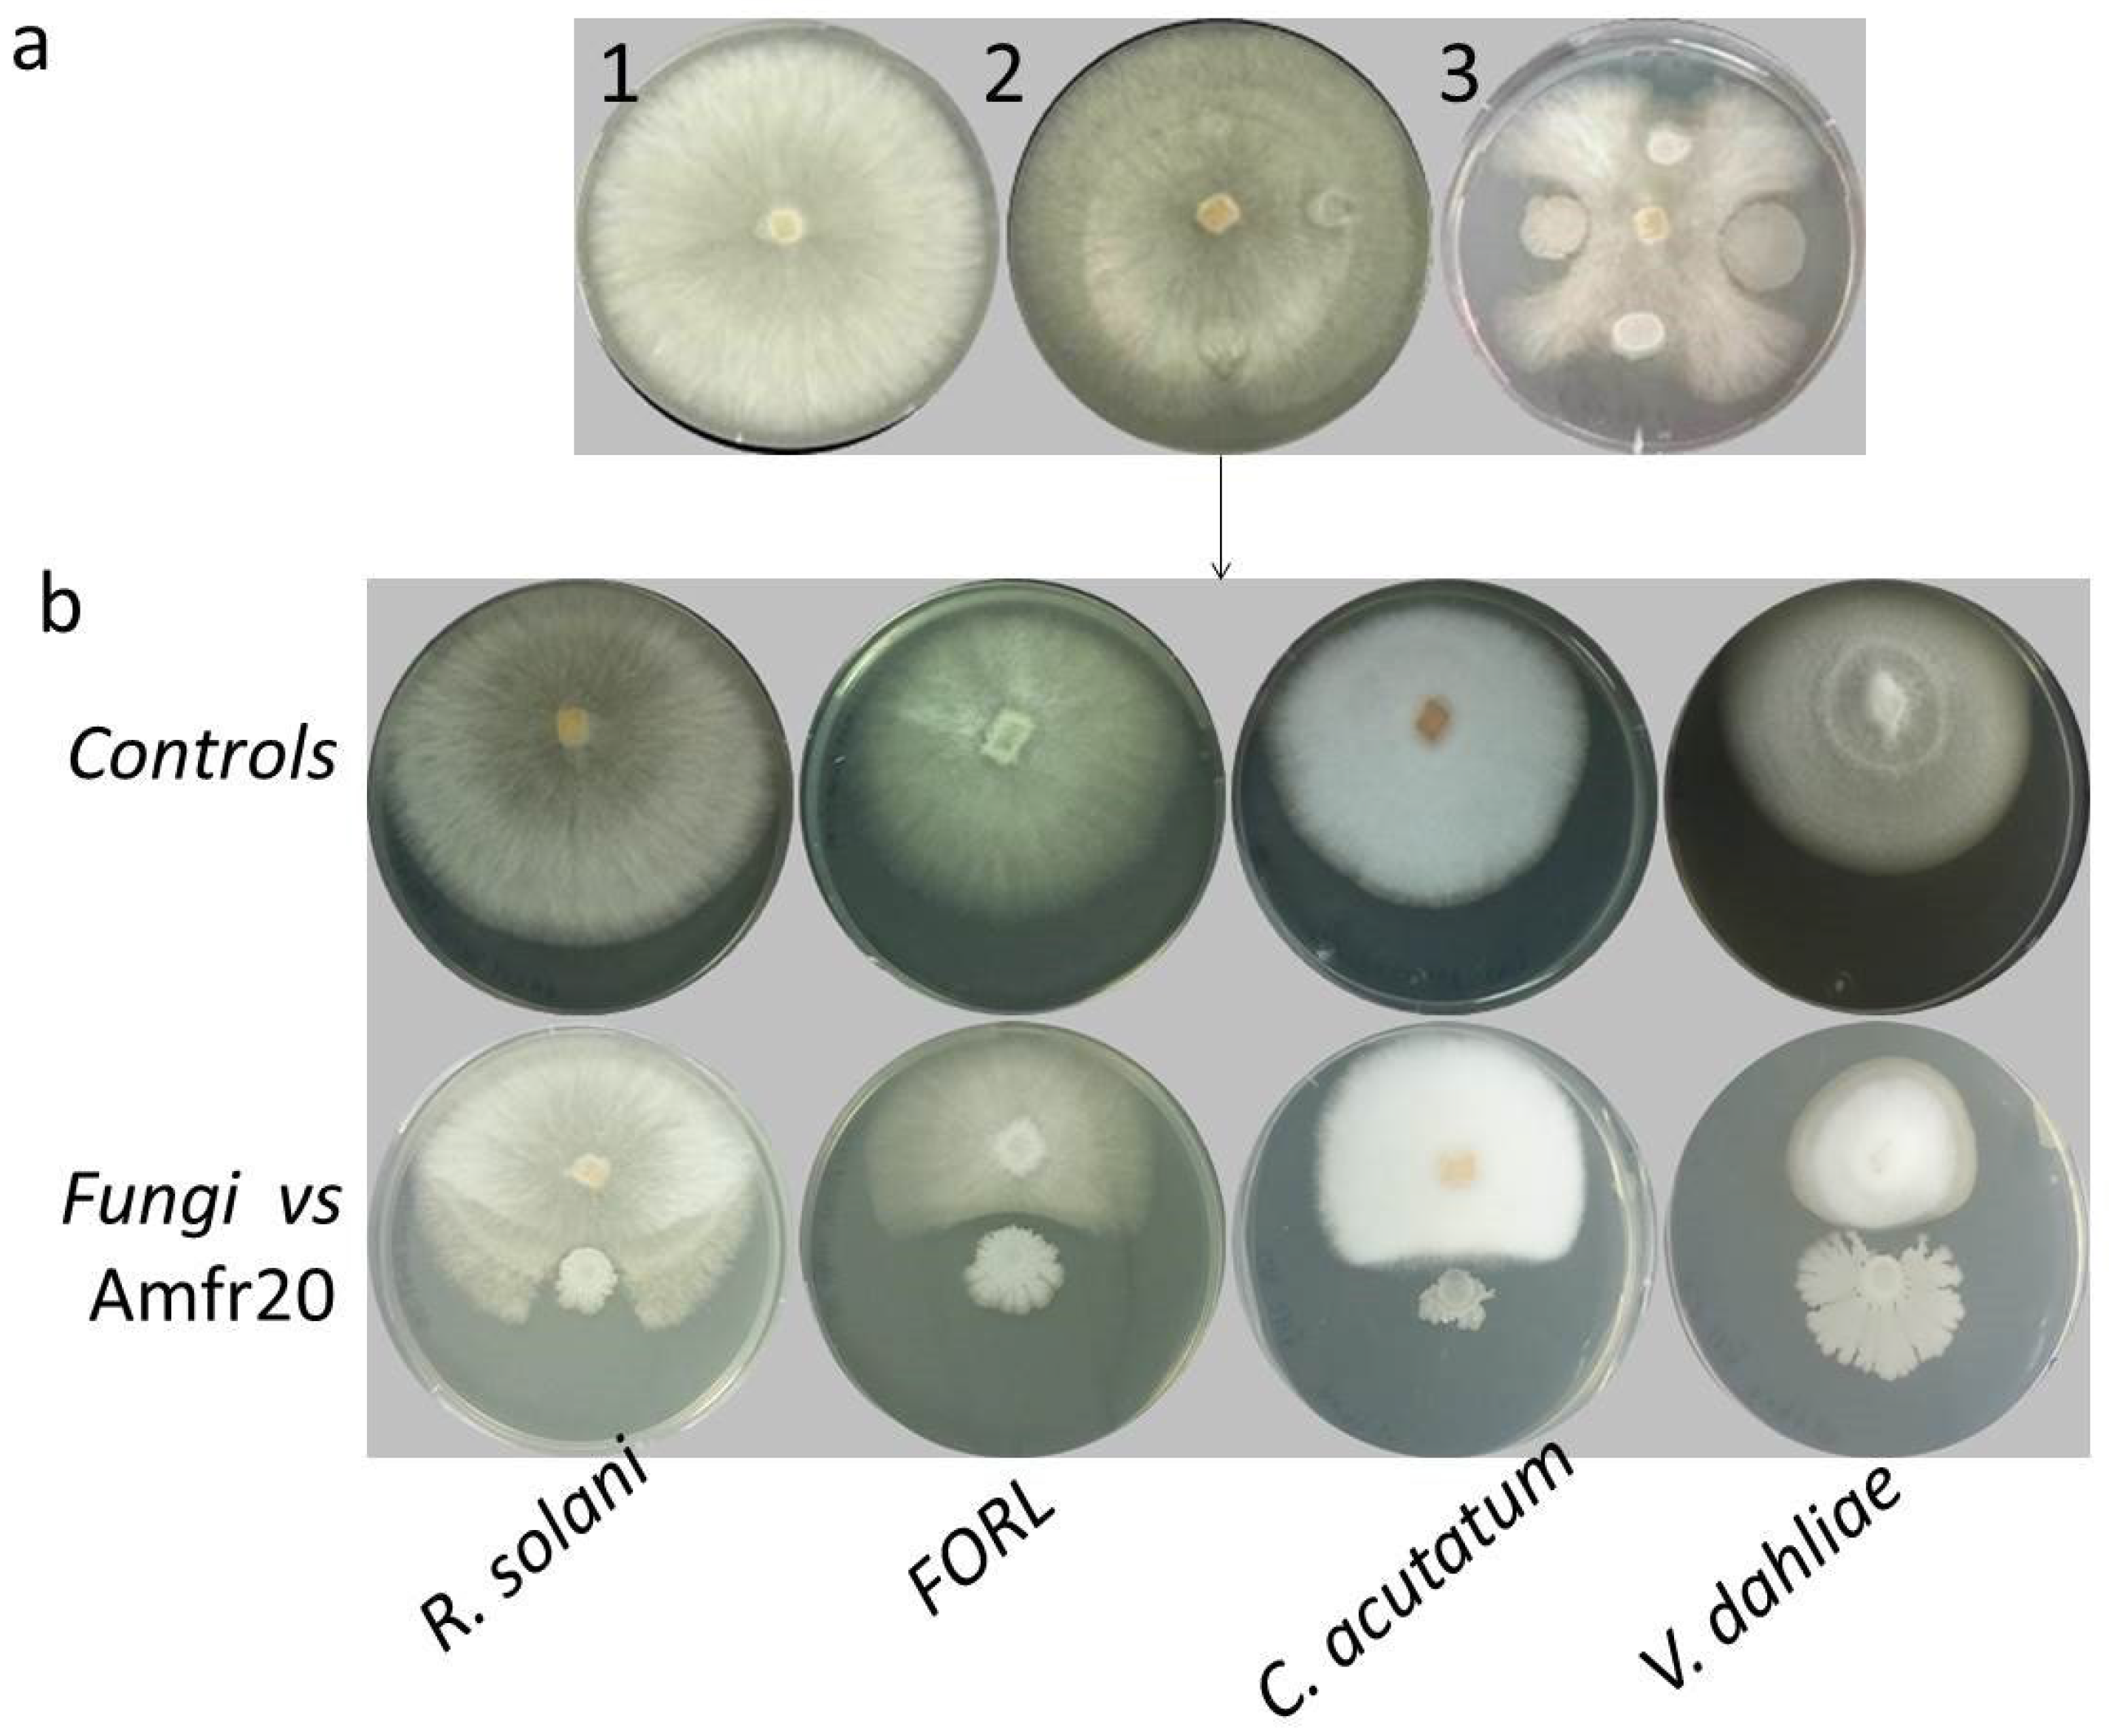
Horticulturae 11 00384 g001
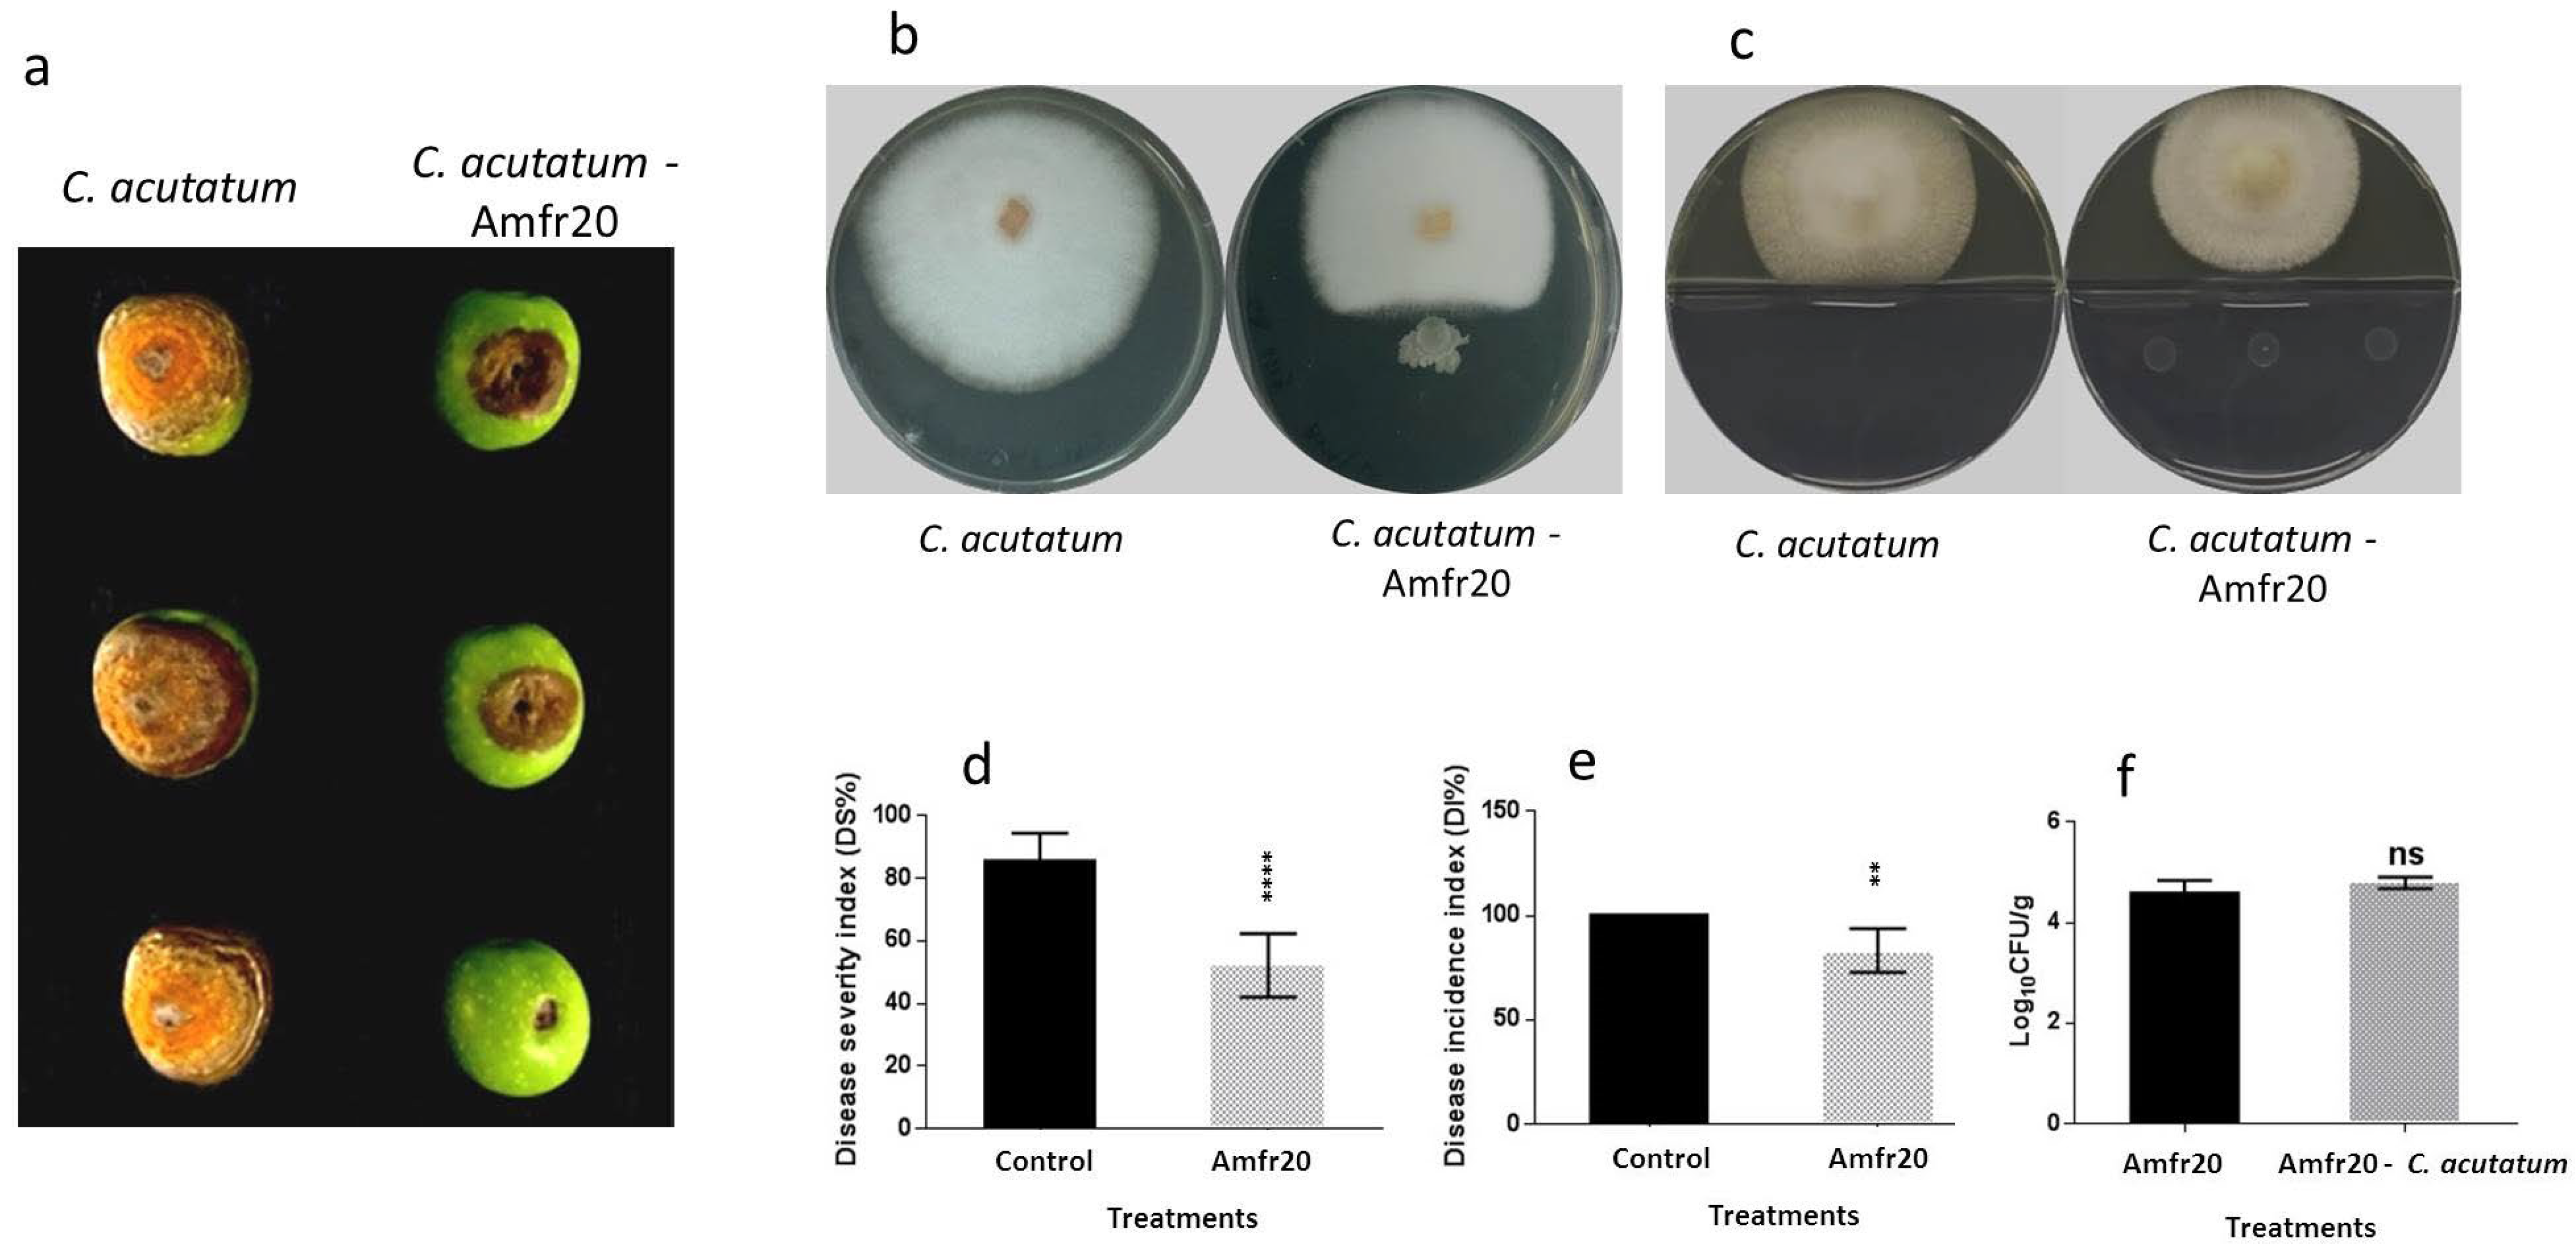
Horticulturae 11 00384 g007

Genomic Insights into Plant Growth Promotion and Biocontrol of Bacillus velezensis Amfr20, an Olive Tree Endophyte
Abstract
1. Introduction
2. Methodological Techniques and Materials
2.1. Sample Collection and Isolation of Bacterial Isolates
2.2. In Vitro Characterization of the Strain Amfr20
2.2.1. In Vitro Antagonistic Activity
2.2.2. PGP and Environmental Fitting Traits
2.2.3. Abiotic Stress Traits
2.2.4. Antibiotic Susceptibility Assay
2.3. Examination of Antagonistic Activity Against Post-Harvest Diseases upon Detached Fruits
2.4. TLC-Bioautography Assay
2.5. Plant Growth Promoting Activity on A. thaliana Col-0 Seedlings In Vitro
2.6. Plant Growth Promoting Activity on Solanum lycopersicum
2.6.1. Bacterial Effect on the Seeding Dynamics of Tomato Seeds Using the Biopriming Method
2.6.2. Plant Growth Promoting Effect on Plant Pots
2.7. Phylogenetic Taxonomy According to 16S rRNA Amplicon
2.8. Whole-Genome Sequencing
2.9. Statistical Analysis
3. Results
3.1. Isolation of Bacterial Endophytes from Olea europaea L. var. Amfissa and Selection of the Most Promising Antagonistic Strain
3.2. In Vitro Characterization of Bacterial Strain Amfr20
3.2.1. Biological Control Activity
3.2.2. Plant Growth Promoting Properties
3.2.3. Abiotic Strain Tolerance
3.2.4. Antibiotic Susceptibility
3.3. Phylogenomic Classification of Bacterial Strain Amfr20
3.4. Prediction of Biosynthetic Gene Clusters of Secondary Metabolites
3.5. Genetic Features of Bacterial Strain Amfr20 as a Potential Plant Growth Promoter and Biological Control Agent
3.6. Examination of In Vivo Biological Control Activity of the Amfr20 Strain upon Artificially Infected Detached Fruits
3.7. TLC-Bioautography Development of Potential Bioactive Secreted Compounds from Solid Culture Against Postharvest B. cinerea
3.8. Investigation of In Vitro Plant Growth-Promoting Ability of the Amfr20 Strain on the Model Plant A. thaliana Under Normal and Saline Conditions
3.9. Plant Growth-Promoting Effect of the Amfr20 Strain on Solanum lycopersicum
4. Discussion
5. Conclusions
Supplementary Materials
Author Contributions
Funding
Data Availability Statement
Conflicts of Interest
References
- Naik, K.; Mishra, S.; Srichandan, H.; Singh, P.K.; Sarangi, P.K. Plant growth promoting microbes: Potential link to sustainable agriculture and environment. Biocatal. Agric. Biotechnol. 2019, 21, 101326. [Google Scholar]
- Barzman, M.; Bàrberi, P.; Birch, A.N.E.; Boonekamp, P.; Dachbrodt-Saaydeh, S.; Graf, B.; Hommel, B.; Jensen, J.E.; Kiss, J.; Kudsk, P.; et al. Eight principles of integrated pest management. Agron. Sustain. Dev. 2015, 35, 1199–1215. [Google Scholar]
- Miliute, I.; Buzaite, O.; Baniulis, D.; Stanys, V. Bacterial endophytes in agricultural crops and their role in stress tolerance: A review. Zemdirbyste 2015, 102, 465–478. [Google Scholar]
- Liu, H.; Carvalhais, L.C.; Crawford, M.; Singh, E.; Dennis, P.G.; Pieterse, C.M.J.; Schenk, P.M. Inner plant values: Diversity, colonization and benefits from endophytic bacteria. Fron. Microbiol. 2017, 8, 2552. [Google Scholar] [CrossRef]
- Popp, J.; Pető, K.; Nagy, J. Pesticide productivity and food security. A review. Agron. Sustain. Dev. 2013, 33, 243–255. [Google Scholar]
- Deng, S.; Wipf, H.M.L.; Pierroz, G.; Raab, T.K.; Khanna, R.; Coleman-Derr, D. A Plant Growth-Promoting Microbial Soil Amendment Dynamically Alters the Strawberry Root Bacterial Microbiome. Sci. Rep. 2019, 9, 17677. [Google Scholar] [CrossRef]
- Trivedi, P.; Trivedi, C.; Grinyer, J.; Anderson, I.C.; Singh, B.K. Harnessing host-vector microbiome for sustainable plant disease management of phloem-limited bacteria. Front. Plant Sci. 2016, 7, 1423. [Google Scholar]
- Reinhold-Hurek, B.; Hurek, T. Living inside plants: Bacterial endophytes. Curr. Opin. Plant Biol. 2011, 14, 435–443. [Google Scholar]
- Shah, A.; Nazari, M.; Antar, M.; Msimbira, L.A.; Naamala, J.; Lyu, D.; Rabileh, M.; Zajonc, J.; Smith, D.L. PGPR in agriculture: A sustainable approach to increasing climate change resilience. Front. Sustain. Food Syst. 2021, 5, 667546. [Google Scholar]
- El-Saadony, M.T.; Saad, A.M.; Soliman, S.M.; Salem, H.M.; Ahmed, A.I.; Mahmood, M.; El-Tahan, A.M.; Ebrahim, A.A.M.; Abd El-Mageed, T.A.; Negm, S.H.; et al. Plant growth-promoting microorganisms as biocontrol agents of plant diseases: Mechanisms, challenges and future perspectives. Front. Plant Sci. 2022, 13, 923880. [Google Scholar] [CrossRef]
- Kumar, M.; Ahmad, S.; Singh, R.P. Plant growth promoting microbes: Diverse roles for sustainable and ecofriendly agriculture. Energy Nexus 2022, 7, 100133. [Google Scholar] [CrossRef]
- Stamenković, S.; Beškoski, V.; Karabegović, I.; Lazić, M.; Nikolić, N. Microbial fertilizers: A comprehensive review of current findings and future perspectives. Span. J. Agric. Res. 2018, 16, e09R01. [Google Scholar] [CrossRef]
- Abhilash, P.C.; Dubey, R.K.; Tripathi, V.; Gupta, V.K.; Singh, H.B. Plant growth-promoting microorganisms for environmental sustainability. Trends Biotechnol. 2016, 34, 847–850. [Google Scholar] [CrossRef] [PubMed]
- Dame, Z.T.; Rahman, M.; Islam, T. Bacilli as sources of agrobiotechnology: Recent advances and future directions. Green Chem. Lett. Rev. 2021, 14, 246–271. [Google Scholar] [CrossRef]
- Etesami, H.; Jeong, B.R.; Glick, B.R. Biocontrol of plant diseases by Bacillus spp. Physiol. Mol. Plant Pathol. 2023, 126, 102048. [Google Scholar] [CrossRef]
- Etesami, H.; Jeong, B.R.; Glick, B.R. Potential use of Bacillus spp. as an effective biostimulant against abiotic stresses in crops—A review. Curr. Res. Biotechnol. 2023, 5, 100128. [Google Scholar] [CrossRef]
- Tsotetsi, T.; Nephali, L.; Malebe, M.; Tugizimana, F. Bacillus for plant growth promotion and stress resilience: What have we learned? Plants 2022, 11, 2482. [Google Scholar] [CrossRef]
- Radhakrishnan, R.; Hashem, A.; AbdAllah, E.F. Bacillus: A biological tool for crop improvement through bio-molecular changes in adverse environments. Front. Physiol. 2017, 8, 667. [Google Scholar] [CrossRef]
- Shafi, J.; Tian, H.; Ji, M. Bacillus species as versatile weapons for plant pathogens: A review. Biotechnol. Biotechnol. Equip. 2017, 31, 446–459. [Google Scholar] [CrossRef]
- Fan, B.; Wang, C.; Song, X.; Ding, X.; Wu, L.; Wu, H.; Gao, X.; Borriss, R. Bacillus velezensis FZB42 in 2018: The gram-positive model strain for plant growth promotion and biocontrol. Front. Microbiol. 2018, 9, 2491. [Google Scholar] [CrossRef]
- Ryu, C.M.; Farag, M.A.; Hu, C.H.; Reddy; Wei, H.X.; Paré, P.W.; Kloepper, J.W. Bacterial volatiles promote growth in Arabidopsis. Proc. Natl. Acad. Sci. USA 2003, 100, 4927–4932. [Google Scholar] [CrossRef] [PubMed]
- Ryu, C.M.; Farag, M.A.; Hu, C.H.; Reddy, M.S.; Kloepper, J.W.; Paré, P.W. Bacterial volatiles induce systemic resistance in Arabidopsis. Plant Physiol. 2004, 134, 1017–1026. [Google Scholar] [CrossRef] [PubMed]
- Kilian, M.; Steiner, U.; Krebs, B.; Junge, H.; Schmiedeknecht, G.; Hain, R. FZB24® Bacillus subtilis–mode of action of a microbial agent enhancing plant vitality. Bayer. CropSci. J. 2000, 1, 1. [Google Scholar]
- Yao, A.V.; Bochow, H.; Karimov, S.; Boturov, U.; Sanginboy, S.; Sharipov, A.K. Effect of FZB 24® Bacillus subtilis as a biofertilizer on cotton yields in field tests. Arch. Phytopathol. Plant Prot. 2006, 39, 323–328. [Google Scholar] [CrossRef]
- Wani, P.A.; Khan, M.S.; Zaidi, A. Synergistic effects of the PGPR and salt-tolerant bacteria on growth and physiological attributes of plants under salt stress. Curr. Microbiol. 2020, 77, 3654–3665. [Google Scholar]
- Zhang, H.; Kim, M.S.; Sun, Y.; Dowd, S.E.; Shi, H.; Paré, P.W. Soil bacteria confer plant salt tolerance by tissue-specific regulation of the sodium transporter HKT1. Mol. Plant Microbe Interact. 2007, 20, 1328–1334. [Google Scholar] [CrossRef]
- Bizos, G.; Papatheodorou, E.M.; Chatzistathis, T.; Ntalli, N.; Aschonitis, V.G.; Monokrousos, N. The role of microbial inoculants on plant protection, growth stimulation, and crop productivity of the olive tree (Olea europea L.). Plants 2020, 9, 743. [Google Scholar] [CrossRef]
- Aranda, S.; Montes-Borrego, M.; Jiménez-Díaz, R.M.; Landa, B.B. Microbial communities associated with the root system of wild olives (Olea europaea L. subsp. europaea var. sylvestris) are good reservoirs of bacteria with antagonistic potential against Verticillium dahliae. Plant Soil. 2011, 343, 329–345. [Google Scholar] [CrossRef]
- Etminani, F.; Harighi, B. Isolation and identification of endophytic bacteria with plant growth promoting activity and biocontrol potential from wild pistachio trees. Plant Pathol. J. 2018, 34, 208. [Google Scholar] [CrossRef]
- Izumi, H.; Anderson, I.C.; Killham, K.; Moore, E.R. Diversity of predominant endophytic bacteria in European deciduous and coniferous trees. Can. J. Microbiol. 2008, 54, 173–179. [Google Scholar] [CrossRef]
- Diez, C.M.; Trujillo, I.; Martinez-Urdiroz, N.; Barranco, D.; Rallo, L.; Marfil, P.; Gaut, B.S. Olive domestication and diversification in the Mediterranean Basin. New Phytol. 2015, 206, 436–447. [Google Scholar] [CrossRef] [PubMed]
- Krid, S.; Rhouma, A.; Mogou, I.; Quesada, J.M.; Nesme, X.; Gargouri, A. Pseudomonas savastanoi endophytic bacteria in olive tree knots and antagonistic potential of strains of Pseudomonas fluorescens and Bacillus subtilis. J. Plant Pathol. 2010, 92, 335–341. [Google Scholar]
- Müller, H.; Berg, C.; Landa, B.B.; Auerbach, A.; Moissl-Eichinger, C.; Berg, G. Plant genotype-specific archaeal and bacterial endophytes but similar Bacillus antagonists colonize Mediterranean olive trees. Front. Microbiol. 2015, 6, 138. [Google Scholar] [CrossRef] [PubMed]
- Cheffi, M.; Chenari Bouket, A.; Alenezi, F.N.; Luptakova, L.; Belka, M.; Vallat, A.; Rateb, M.E.; Tounsi, S.; Triki, M.A.; Belbahri, L. Olea europaea L. root endophyte Bacillus velezensis OEE1 counteracts oomycete and fungal harmful pathogens and harbours a large repertoire of secreted and volatile metabolites and beneficial functional genes. Microorganisms 2019, 7, 314. [Google Scholar] [CrossRef]
- Castro, D.; Torres, M.; Sampedro, I.; Martínez-Checa, F.; Torres, B.; Béjar, V. Biological control of Verticillium wilt on olive trees by the salt-tolerant strain Bacillus velezensis XT1. Microorganisms 2020, 8, 1080. [Google Scholar] [CrossRef]
- Zicca, S.; De Bellis, P.; Masiello, M.; Saponari, M.; Saldarelli, P.; Boscia, D.; Sisto, A. Antagonistic activity of olive endophytic bacteria and of Bacillus spp. strains against Xylella fastidiosa. Microbiol. Res. 2020, 236, 126467. [Google Scholar] [CrossRef]
- Azabou, M.C.; Gharbi, Y.; Medhioub, I.; Ennouri, K.; Barham, H.; Tounsi, S.; Triki, M.A. The endophytic strain Bacillus velezensis OEE1: An efficient biocontrol agent against Verticillium wilt of olive and a potential plant growth promoting bacteria. Biol. Control. 2020, 142, 104168. [Google Scholar]
- Dias, M.C.; Araújo, M.; Ma, Y. A bio-based strategy for sustainable olive performance under water deficit conditions. Plant Stress 2024, 11, 100342. [Google Scholar] [CrossRef]
- Kusari, S.; Hertweck, C.; Spiteller, M. Chemical ecology of endophytic fungi: Origins of secondary metabolites. Chem. Biol. 2012, 19, 792–798. [Google Scholar] [CrossRef]
- Schwyn, B.; Neilands, J.B. Universal chemical assay for the detection and determination of siderophores. Anal. Biochem. 1987, 160, 47–56. [Google Scholar] [CrossRef]
- Pikovskaya, R.I. Mobilization of Phosphorus in Soil Connection with the Vital Activity of Some Microbial Species. Microbiology 1948, 17, 362–370. [Google Scholar]
- Kumar, R.S.; Ayyadurai, N.; Pandiaraja, P.; Reddy, A.V.; Reddy, A.V.; Venkateswarlu, Y.; Prakash, O.; Sakthivel, N. Characterization of antifungal metabolite produced by a new strain Pseudomonasaeruginosa PUPa3 that exhibits broad-spectrum antifungal activity and biofertilizing traits. J. Appl. Microbiol. 2005, 98, 145–154. [Google Scholar] [PubMed]
- Mobley, H.L.; Hausinger, R.P. Microbial ureases: Significance, regulation, and molecular characterization. Microbiol. Mol. Biol. 1989, 53, 85–108. [Google Scholar] [CrossRef] [PubMed]
- Baysal, O.; Lai, D.; Xu, H.H.; Siragusa, M.; Calışkan, M.; Carimi, F.; da Silva, J.A.; Tör, M. A proteomic approach provides new insights into the control of soil-borne plant pathogens by Bacillus species. PLoS ONE 2013, 8, e53182. [Google Scholar] [CrossRef]
- O’Toole, G.A.; Kolter, R. Initiation of biofilm formation in Pseudomonas fluorescens WCS365 proceeds via multiple, convergent signalling pathways: A genetic analysis. Mol. Microbiol. 1998, 28, 449–461. [Google Scholar]
- Bauer, A.W.; Kirby, W.M.; Sherris, J.C.; Turck, M. Antibiotic susceptibility testing by a standardized single disk method. Tech. Bull. Regist. Med. Technol. 1966, 45, 493–496. [Google Scholar]
- Bertrand, S.; Schumpp, O.; Bohni, N.; Bujard, A.; Azzollini, A.; Monod, M.; Gindro, K.; Wolfender, J.L. Detection of metabolite induction in fungal co-cultures on solid media by high-throughput differential ultra-high pressure liquid chromatography–time-of-flight mass spectrometry fingerprinting. J. Chromatogr. A 2013, 1292, 219–228. [Google Scholar]
- Costa, O.Y.; Raaijmakers, J.M.; Kuramae, E.E. Microbial extracellular polymeric substances: Ecological function and impact on soil aggregation. Fron. Microbiol. 2018, 9, 1636. [Google Scholar]
- Calvo, H.; Mendiara, I.; Arias, E.; Gracia, A.P.; Blanco, D.; Venturini, M.E. Antifungal activity of the volatile organic compounds produced by Bacillus velezensis strains against postharvest fungal pathogens. Postharvest Biol. Technol. 2020, 166, 111208. [Google Scholar] [CrossRef]
- Palacio-Rodríguez, R.; Coria-Arellano, J.L.; López-Bucio, J.; Sánchez-Salas, J.; Muro-Pérez, G.; Castañeda-Gaytán, G.; Sáenz-Mata, J. Halophilic rhizobacteria from Distichlis spicata promote growth and improve salt tolerance in heterologous plant hosts. Symbiosis 2017, 73, 179–189. [Google Scholar]
- Asari, S.; Matzén, S.; Petersen, M.A.; Bejai, S.; Meijer, J. Multiple effects of Bacillus amyloliquefaciens volatile compounds: Plant growth promotion and growth inhibition of phytopathogens. FEMS Microbiol. Ecol. 2016, 92, fiw070. [Google Scholar] [CrossRef] [PubMed]
- Weisburg, W.G.; Barns, S.M.; Pelletier, D.A.; Lane, D.J. 16S ribosomal DNA amplification for phylogenetic study. J. Bacteriol. 1991, 173, 697–703. [Google Scholar] [CrossRef] [PubMed]
- Kumar, S.; Stecher, G.; Suleski, M.; Sanderford, M.; Sharma, S.; Tamura, K. MEGA12: Molecular Evolutionary Genetic Analysis version 12 for adaptive and green computing. Mol. Biol. Evol. 2024, 41, msae263. [Google Scholar]
- Bankevich, A.; Nurk, S.; Antipov, D.; Gurevich, A.A.; Dvorkin, M.; Kulikov, A.S.; Lesin, V.M.; Nikolenko, S.I.; Pham, S.; Prjibelski, A.D.; et al. SPAdes: A new genome assembly algorithm and its applications to single-cell sequencing. J. Comput. Biol. 2012, 19, 455–477. [Google Scholar] [CrossRef]
- Seemann, T. Prokka: Rapid prokaryotic genome annotation. Bioinformatics 2014, 30, 2068–2069. [Google Scholar]
- Meier-Kolthoff, J.P.; Auch, A.F.; Klenk, H.P.; Göker, M. Genome sequence-based species delimitation with confidence intervals and improved distance functions. BMC bioinform. 2013, 14, 60. [Google Scholar]
- Yoon, S.H.; Ha, S.M.; Kwon, S.; Lim, J.; Kim, Y.; Seo, H.; Chun, J. Introducing EzBioCloud: A taxonomically united database of 16S rRNA gene sequences and whole-genome assemblies. Int. J. Syst. Evol. Microbiol. 2017, 67, 1613. [Google Scholar]
- Lefort, V.; Desper, R.; Gascuel, O. FastME 2.0: A comprehensive, accurate, and fast distance-based phylogeny inference program. Mol. Biol. Evol. 2015, 32, 2798–2800. [Google Scholar]
- Richter, M.; Rosselló-Móra, R. Shifting the genomic gold standard for the prokaryotic species definition. Proc. Natl. Acad. Sci. USA 2009, 106, 19126–19131. [Google Scholar] [CrossRef]
- Wayne, L.G.; Brenner, D.; Colwell, R.R.; Grimont, P.A.D.; Kandler, O.; Krichevsky, M.I.; Moore, L.H.; Moore, W.E.C.; Murray, R.G.E.; Stackebrandt, E.; et al. Report of the ad hoc committee on reconciliation of approaches to bacterial systematics. Int. J. Sys. Evol. Microbiol. 1987, 37, 463–464. [Google Scholar]
- Compant, S.; Samad, A.; Faist, H.; Sessitsch, A. A review on the plant microbiome: Ecology, functions, and emerging trends in microbial application. J. Adv. Res. 2019, 19, 29–37. [Google Scholar] [PubMed]
- Mendes, R.; Garbeva, P.; Raaijmakers, J.M. The rhizosphere microbiome: Significance of plant beneficial, plant pathogenic, and human pathogenic microorganisms. FEMS Microbiol. Rev. 2013, 37, 634–663. [Google Scholar] [CrossRef] [PubMed]
- White, J.F.; Kingsley, K.L.; Zhang, Q.; Verma, R.; Obi, N.; Dvinskikh, S.; Elmore, M.T.; Verma, S.K.; Gond, S.K.; Kowalski, K.P. Endophytic microbes and their potential applications in crop management. Pest Manag. Sci. 2019, 75, 2558–2565. [Google Scholar] [PubMed]
- Eid, A.M.; Fouda, A.; Abdel-Rahman, M.A.; Salem, S.S.; Elsaied, A.; Oelmüller, R.; Hijri, M.; Bhowmik, A.; Elkelish, A.; Hassan, S.E.-D. Harnessing bacterial endophytes for promotion of plant growth and biotechnological applications: An overview. Plants 2021, 10, 935. [Google Scholar] [CrossRef]
- Lacava, P.T.; Bogas, A.C.; Cruz, F.D.P.N. Plant growth promotion and biocontrol by endophytic and rhizospheric microorganisms from the tropics: A review and perspectives. Front. Sustain. Food Syst. 2022, 6, 796113. [Google Scholar] [CrossRef]
- Iatrou, G.; Mourelatos, S.; Zartaloudis, Z.; Iatrou, M.; Gewehr, S.; Kalaitzopoulou, S. Remote sensing for the management of Verticillium wilt of olive. Fresenius Environ. Bull. 2016, 25, 3622–3628. [Google Scholar]
- Montes-Osuna, N.; Mercado-Blanco, J. Verticillium wilt of olive and its control: What did we learn during the last decade? Plants 2020, 9, 735. [Google Scholar] [CrossRef]
- Talhinhas, P.; Loureiro, A.; Oliveira, H. Olive anthracnose: A yield-and oil quality-degrading disease caused by several species of Colletotrichum that differ in virulence, host preference and geographical distribution. Mol. Plant Pathol. 2018, 19, 1797–1807. [Google Scholar] [CrossRef]
- Hamdache, A.; Azarken, R.; Lamarti, A.; Aleu, J.; Collado, I.G. Comparative genome analysis of Bacillus spp. and its relationship with bioactive nonribosomal peptide production. Phytochem. Rev. 2013, 12, 685–716. [Google Scholar]
- Dunlap, C.A.; Kim, S.J.; Kwon, S.W.; Rooney, A.P. Bacillus velezensis is not a later heterotypic synonym of Bacillus amyloliquefaciens; Bacillus methylotrophicus, Bacillus amyloliquefaciens subsp. plantarum and Bacillus oryzicola are later heterotypic synonyms of Bacillus velezensis based on phylogenomics. Int. J. Syst. Evol. Microbiol. 2016, 66, 1212–1217. [Google Scholar]
- Dunlap, C.A. Taxonomy of registered Bacillus spp. strains used as plant pathogen antagonists. Biol. Control. 2019, 134, 82–86. [Google Scholar] [CrossRef]
- Miljaković, D.; Marinković, J.; Balešević-Tubić, S. The significance of Bacillus spp. in disease suppression and growth promotion of field and vegetable crops. Microorganisms 2020, 8, 1037. [Google Scholar] [CrossRef] [PubMed]
- Khan, A.R.; Mustafa, A.; Hyder, S.; Valipour, M.; Rizvi, Z.F.; Gondal, A.S.; Yousuf, Z.; Iqbal, R.; Daraz, U. Bacillus spp. as bioagents: Uses and application for sustainable agriculture. Biology 2022, 11, 1763. [Google Scholar] [CrossRef] [PubMed]
- Rabbee, M.F.; Hwang, B.S.; Baek, K.H. Bacillus velezensis: A Beneficial Biocontrol Agent or Facultative Phytopathogen for Sustainable Agriculture. Agronomy 2023, 13, 840. [Google Scholar] [CrossRef]
- Rabbee, M.F.; Ali, M.S.; Choi, J.; Hwang, B.S.; Jeong, S.C.; Baek, K.-H. Bacillus velezensis: A valuable member of bioactive molecules within plant microbiomes. Molecules 2019, 24, 1046. [Google Scholar] [CrossRef]
- Pan, L.; Cai, B. Phosphate-Solubilizing Bacteria: Advances in Their Physiology, Molecular Mechanisms and Microbial Community Effects. Microorganisms 2023, 11, 2904. [Google Scholar] [CrossRef]
- Vuolanto, A.; von Weymarn, N.; Kerovuo, J.; Ojamo, H.; Leisola, M. Phytase production by high cell density culture of recombinant Bacillus subtilis. Biotechnol. Lett. 2001, 23, 761–766. [Google Scholar] [CrossRef]
- Qin, Y.; He, Y.; She, Q.; Larese-Casanova, P.; Li, P.; Chai, Y. Heterogeneity in respiratory electron transfer and adaptive iron utilization in a bacterial biofilm. Nat. Commun. 2019, 10, 3702. [Google Scholar] [CrossRef]
- Szigeti, R.; Milescu, M.; Gollnick, P. Regulation of the tryptophan biosynthetic genes in Bacillus halodurans: Common elements but different strategies than those used by Bacillus subtilis. J. Bacteriol. 2004, 186, 818–828. [Google Scholar] [CrossRef]
- Shao, J.; Li, S.; Zhang, N.; Cui, X.; Zhou, X.; Zhang, G.; Shen, Q.; Zhang, R. Analysis and cloning of the synthetic pathway of the phytohormone indole-3-acetic acid in the plant-beneficial Bacillus amyloliquefaciens SQR9. Microb. Cell Factories 2015, 14, 130. [Google Scholar] [CrossRef]
- Kearns, D.B.; Chu, F.; Rudner, R.; Losick, R. Genes governing swarming in Bacillus subtilis and evidence for a phase variation mechanism controlling surface motility. Mol. Microbiol. 2004, 52, 357–369. [Google Scholar] [PubMed]
- Tahir, U.; Aslam, F.; Nawaz, S.; Khan, U.H.; Yasmin, A. Annotation of chemotaxis gene clusters and proteins involved in chemotaxis of Bacillus subtilis strain MB378 capable of biodecolorizing different dyes. Environ. Sci. Pollut. Res. 2022, 29, 3510–3520. [Google Scholar] [CrossRef] [PubMed]
- Carabetta, V.J.; Tanner, A.W.; Greco, T.M.; Defrancesco, M.; Cristea, I.M.; Dubnau, D. A complex of YlbF, YmcA and YaaT regulates sporulation, competence and biofilm formation by accelerating the phosphorylation of Spo0A. Mol. Microbiol. 2013, 88, 283–300. [Google Scholar] [PubMed]
- Winkelman, J.T.; Bree, A.C.; Bate, A.R.; Eichenberger, P.; Gourse, R.L.; Kearns, D.B. RemA is a DNA-binding protein that activates biofilm matrix gene expression in Bacillus subtilis. Mol. Microbiol. 2013, 88, 984–997. [Google Scholar]
- Leiman, S.A.; Arboleda, L.C.; Spina, J.S.; McLoon, A.L. SinR is a mutational target for fine-tuning biofilm formation in laboratory-evolved strains of Bacillussubtilis. BMC Microbiol. 2014, 14, 301. [Google Scholar]
- Liu, Y.; Shi, H.; Wang, Z.; Huang, X.; Zhang, X. Pleiotropic control of antibiotic biosynthesis, flagellar operon expression, biofilm formation, and carbon source utilization by RpoN in Pseudomonas protegens H78. Appl. Microbiol. Biotechnol. 2018, 102, 9719–9730. [Google Scholar] [CrossRef]
- Pourciau, C.; Lai, Y.J.; Gorelik, M.; Babitzke, P.; Romeo, T. Diverse mechanisms and circuitry for global regulation by the RNA-binding protein CsrA. Front. Microbiol. 2020, 11, 601352. [Google Scholar] [CrossRef]
- Raj, C.D.; Suryavanshi, M.V.; Kandaswamy, S.; Ramasamy, K.P.; James, R.A. Whole genome sequence analysis and in-vitro probiotic characterization of Bacillus velezensis FCW2 MCC4686 from spontaneously fermented coconut water. Genomics 2023, 115, 110637. [Google Scholar]
- Chen, B.; Zhou, Y.; Duan, L.; Gong, X.; Liu, X.; Pan, K.; Zeng, D.; Ni, X.; Zeng, Y. Complete genome analysis of Bacillus velezensis TS5 and its potential as a probiotic strain in mice. Front. Microbiol. 2023, 14, 1322910. [Google Scholar]
- Xu, W.; Yang, Q.; Yang, F.; Xie, X.; Goodwin, P.H.; Deng, X.; Tian, B.; Yang, L. Evaluation and genome analysis of Bacillus subtilis YB-04 as a potential biocontrol agent against Fusarium wilt and growth promotion agent of cucumber. Front. Microbiol. 2022, 13, 885430. [Google Scholar]
- Yang, F.; Jiang, H.; Ma, K.; Wang, X.; Liang, S.; Cai, Y.; Jing, Y.; Tian, B.; Shi, X. Genome sequencing and analysis of Bacillus velezensis VJH504 reveal biocontrol mechanism against cucumber Fusarium wilt. Front. Microbiol. 2023, 14, 1279695. [Google Scholar] [CrossRef] [PubMed]
- Thomloudi, E.-E.; Tsalgatidou, P.C.; Baira, E.; Papadimitriou, K.; Venieraki, A.; Katinakis, P. Genomic and Metabolomic Insights into Secondary Metabolites of the Novel Bacillus halotolerans Hil4, an Endophyte with Promising Antagonistic Activity Against Gray Mold and Plant Growth Promoting Potential. Microorganisms 2021, 9, 2508. [Google Scholar] [CrossRef] [PubMed]
- Guo, J.; Cheng, Y. Advances in fungal elicitor-triggered plant immunity. Int. J. Mol. Sci. 2022, 23, 12003. [Google Scholar] [CrossRef] [PubMed]
- Dietrich, R.; Ploss, K.; Heil, M. Constitutive and induced resistance to pathogens in Arabidopsis thaliana depends on nitrogen supply. Plant Cell Environ. 2004, 27, 896–906. [Google Scholar] [CrossRef]
- Chen, X.H.; Koumoutsi, A.; Scholz, R.; Eisenreich, A.; Schneider, K.; Heinemeyer, I.; Morgenstern, B.; Voss, B.; Hess, W.R.; Reva, O.; et al. Comparative analysis of the complete genome sequence of the plant growth–promoting bacterium Bacillus amyloliquefaciens FZB42. Nat. Biotechnol. 2007, 25, 1007–1014. [Google Scholar] [CrossRef]
- Fazle Rabbee, M.; Baek, K.H. Antimicrobial activities of lipopeptides and polyketides of Bacillus velezensis for agricultural applications. Molecules 2020, 25, 4973. [Google Scholar] [CrossRef]
- Miethke, M.; Klotz, O.; Linne, U.; May, J.J.; Beckering, C.L.; Marahiel, M.A. Ferri-bacillibactin uptake and hydrolysis in Bacillus subtilis. Mol. Microbiol. 2006, 61, 1413–1427. [Google Scholar] [CrossRef]
- Islam, T.; Rabbee, M.F.; Choi, J.; Baek, K.H. Biosynthesis, molecular regulation, and application of bacilysin produced by Bacillus species. Metabolites 2022, 12, 397. [Google Scholar] [CrossRef]
- Wu, L.; Wu, H.; Chen, L.; Yu, X.; Borriss, R.; Gao, X. Difficidin and bacilysin from Bacillus amyloliquefaciens FZB42 have antibacterial activity against Xanthomonas oryzae rice pathogens. Sci. Rep. 2015, 5, 12975. [Google Scholar] [CrossRef]
- Chen, X.H.; Scholz, R.; Borriss, M.; Junge, H.; Mögel, G.; Kunz, S.; Borriss, R. Difficidin and bacilysin produced by plant-associated Bacillus amyloliquefaciens are efficient in controlling fire blight disease. J. Biotechnol. 2009, 140, 38–44. [Google Scholar] [CrossRef]
- Han, X.; Shen, D.; Xiong, Q.; Bao, B.; Zhang, W.; Dai, T.; Zhao, Y.; Borriss, R.; Fan, B. The plant-beneficial rhizobacterium Bacillus velezensis FZB42 controls the soybean pathogen Phytophthora sojae due to bacilysin production. Appl. Environ. Microbiol. 2021, 87, e01601–e01621. [Google Scholar] [PubMed]
- Patel, P.S.; Huang, S.; Fisher, S.; Pirnik, D.; Aklonis, C.; Dean, L.; Meyers, E.; Fernandes, P.; Mayerl, F. Bacillaene, a novel inhibitor of procaryotic protein synthesis produced by Bacillus subtilis: Production, taxonomy, isolation, physico-chemical characterization and biological activity. J. Antibiot. 1995, 48, 997–1003. [Google Scholar] [CrossRef] [PubMed]
- Zhao, X.; Kuipers, O.P. Identification and classification of known and putative antimicrobial compounds produced by a wide variety of Bacillales species. BMC Genom. 2016, 17, 882. [Google Scholar]
- Chen, X.H.; Vater, J.; Piel, J.; Franke, P.; Scholz, R.; Schneider, K.; Koumoutsi, A.; Hitzeroth, G.; Grammel, N.; Strittmatter, A.W.; et al. Structural and functional characterization of three polyketide synthase gene clusters in Bacillus amyloliquefaciens FZB42. J. Bacteriol. 2006, 188, 4024–4036. [Google Scholar]
- Scholz, R.; Vater, J.; Budiharjo, A.; Wang, Z.; He, Y.; Dietel, K.; Schwecke, T.; Herfort, S.; Lasch, P.; Borriss, R. Amylocyclicin, a novel circular bacteriocin produced by Bacillus amyloliquefaciens FZB42. J. Bacteriol. 2014, 196, 1842–1852. [Google Scholar]
- Tran, C.; Cock, I.E.; Chen, X.; Feng, Y. Antimicrobial Bacillus: Metabolites and their mode of action. Antibiotics 2022, 11, 88. [Google Scholar] [CrossRef]
- Herzner, A.M.; Dischinger, J.; Szekat, C.; Josten, M.; Schmitz, S.; Yakéléba, A.; Reinartz, R.; Jansen, A.; Sahl, H.G.; Piel, J.; et al. Expression of the lantibiotic mersacidin in Bacillus amyloliquefaciens FZB42. PLoS ONE 2011, 6, e22389. [Google Scholar] [CrossRef]
- Valenzuela Ruiz, V.; Gándara-Ledezma, A.; Villarreal-Delgado, M.F.; Villa-Rodríguez, E.D.; Parra-Cota, F.I.; Santoyo, G.; Gómez-Godínez, L.J.; Cira Chávez, L.A.; de los Santos-Villalobos, S. Regulation, Biosynthesis, and Extraction of Bacillus-Derived Lipopeptides and Its Implications in Biological Control of Phytopathogens. Stresses 2024, 4, 107–132. [Google Scholar] [CrossRef]
- Ranjan, A.; Rajput, V.D.; Prazdnova, E.V.; Gurnani, M.; Bhardwaj, P.; Sharma, S.; Sushkova, S.; Mandzhieva, S.S.; Minkina, T.; Sudan, J.; et al. Nature’s Antimicrobial Arsenal: Non-Ribosomal Peptides from PGPB for Plant Pathogen Biocontrol. Fermentation 2023, 9, 597. [Google Scholar] [CrossRef]
- Ongena, M.; Jacques, P. Bacillus lipopeptides: Versatile weapons for plant disease biocontrol. Trends Microbiol. 2008, 16, 115–125. [Google Scholar]
- Stoll, A.; Salvatierra-Martínez, R.; González, M.; Araya, M. The role of surfactin production by Bacillus velezensis on colonization, biofilm formation on tomato root and leaf surfaces and subsequent protection (ISR) against Botrytis cinerea. Microorganisms 2021, 9, 2251. [Google Scholar] [CrossRef] [PubMed]
- Ongena, M.; Jourdan, E.; Adam, A.; Paquot, M.; Brans, A.; Joris, B.; Arpigny, J.L.; Thonart, P. Surfactin and fengycin lipopeptides of Bacillus subtilis as elicitors of induced systemic resistance in plants. Environ. Microbiol. 2007, 9, 1084–1090. [Google Scholar] [CrossRef] [PubMed]
- Kiesewalter, H.T.; Lozano-Andrade, C.N.; Wibowo, M.; Strube, M.L.; Maróti, G.; Snyder, D.; Jørgensen, T.S.; Larsen, T.O.; Cooper, V.S.; Weber, T.; et al. Genomic and chemical diversity of Bacillus subtilis secondary metabolites against plant pathogenic fungi. Msystems 2021, 6, 10–1128. [Google Scholar] [CrossRef] [PubMed]
- Vahidinasab, M.; Lilge, L.; Reinfurt, A.; Pfannstiel, J.; Henkel, M.; Morabbi Heravi, K.; Hausmann, R. Construction and description of a constitutive plipastatin mono-producing Bacillus subtilis. Microb. Cell Fact. 2020, 19, 205. [Google Scholar] [CrossRef]
- Jin, P.; Wang, H.; Tan, Z.; Xuan, Z.; Dahar, G.Y.; Li, Q.X.; Miao, W.; Liu, W. Antifungal mechanism of bacillomycin D from Bacillus velezensis HN-2 against Colletotrichum gloeosporioides Penz. Pestic. Biochem. Physiol. 2020, 163, 102–107. [Google Scholar] [CrossRef]
- Lin, F.; Huang, Z.; Chen, Y.; Zhou, L.; Chen, M.; Sun, J.; Lu, Z.; Lu, Y. Effect of combined Bacillomycin D and chitosan on growth of Rhizopus stolonifer and Botrytiscinerea and cherry tomato preservation. J. Sci. of Food Agric. 2021, 101, 229–239. [Google Scholar] [CrossRef]
- Wilson, J.; Cui, J.; Nakao, T.; Kwok, H.; Zhang, Y.; Kayrouz, C.M.; Pham, T.M.; Roodhouse, H.; Ju, K.S. Discovery of Antimicrobial Phosphonopeptide Natural Products from Bacillus velezensis by Genome Mining. Appl. Environ. Microbiol. 2023, 89, e00338-23. [Google Scholar] [CrossRef]
- Mullins, A.J.; Li, Y.; Qin, L.; Hu, X.; Xie, L.; Gu, C.; Mahenthiralingam, E.; Liao, X.; Webster, G. Reclassification of the biocontrol agents Bacillus subtilis BY-2 and Tu-100 as Bacillus velezensis and insights into the genomic and specialized metabolite diversity of the species. Microbiology 2020, 166, 1121–1128. [Google Scholar] [CrossRef]
- Kudo, F.; Eguchi, T. Biosynthetic enzymes for the aminoglycosides butirosin and neomycin. Methods Enzymol. 2009, 459, 493–519. [Google Scholar]
- Su, Z.; Liu, G.; Liu, X.; Li, S.; Lu, X.; Wang, P.; Zhao, W.; Zhang, X.; Dong, L.; Qu, Y.; et al. Functional Analyses of the Bacillus velezensis HMB26553 Genome Provide Evidence That Its Genes Are Potentially Related to the Promotion of Plant Growth and Prevention of Cotton Rhizoctonia Damping-Off. Cells 2023, 12, 1301. [Google Scholar] [CrossRef]
- Lastochkina, O.; Seifikalhor, M.; Aliniaeifard, S.; Baymiev, A.; Pusenkova, L.; Garipova, S.; Kulabuhova, D.; Maksimov, I. Bacillus spp.: Efficient biotic strategy to control postharvest diseases of fruits and vegetables. Plants 2019, 8, 97. [Google Scholar] [CrossRef] [PubMed]
- Bonaterra, A.; Badosa, E.; Daranas, N.; Francés, J.; Roselló, G.; Montesinos, E. Bacteria as biological control agents of plant diseases. Microorganisms 2022, 10, 1759. [Google Scholar] [CrossRef] [PubMed]
- Kim, Y.S.; Balaraju, K.; Jeon, Y. Effects of rhizobacteria Paenibacillus polymyxa APEC136 and Bacillus subtilis APEC170 on biocontrol of postharvest pathogens of apple fruits. J. Zhejiang Univ. Sci. B. 2016, 17, 931–940. [Google Scholar] [CrossRef] [PubMed]
- Bu, S.; Munir, S.; He, P.; Li, Y.; Wu, Y.; Li, X.; Kong, B.; He, P.; He, Y. Bacillus subtilis L1-21 as a biocontrol agent for postharvest gray mold of tomato caused by Botrytis cinerea. Biol. Control. 2021, 157, 104568. [Google Scholar] [CrossRef]
- Wang, F.; Xiao, J.; Zhang, Y.; Li, R.; Li, L.; Deng, J. Biocontrol ability and action mechanism of Bacillus halotolerans against Botrytis cinerea causing grey mould in postharvest strawberry fruit. Postharvest Biol. Technol. 2021, 174, 111456. [Google Scholar]
- Zhang, Q.; Chen, Y.S.; Xu, C.Y.; Zou, M.; Bao, W.; Xi, L.; Xin, L.; Chen, Y. Efficacy and action mechanism of Bacillus velezensis on controlling postharvest soft rot of sweet cherryfruits. Shipin Kexue/Food Sci. 2023, 44, 229–239. [Google Scholar]
- Nifakos, K.; Tsalgatidou, P.C.; Thomloudi, E.-E.; Skagia, A.; Kotopoulis, D.; Baira, E.; Delis, C.; Papadimitriou, K.; Markellou, E.; Venieraki, A.; et al. Genomic Analysis and Secondary Metabolites Production of the Endophytic Bacillus velezensis Bvel1: A Biocontrol Agent against Botrytis cinerea Causing Bunch Rot in Post-Harvest Table Grapes. Plants 2021, 10, 1716. [Google Scholar] [CrossRef]
- Papadopoulou, E.A.; Angelis, A.; Antoniadi, L.; Aliferis, K.A.; Skaltsounis, A.L. Discovering the Next-Generation Plant Protection Products: A Proof-of-Concept via the Isolation and Bioactivity Assessment of the Olive Tree Endophyte Bacillus sp. PTA13 Lipopeptides. Metabolites 2021, 11, 833. [Google Scholar] [CrossRef]
- Taha, N.A.; Elsharkawy, M.M.; Shoughy, A.A.; El-Kazzaz, M.K.; Khedr, A.A. Biological control of postharvest tomato fruit rots using Bacillus spp. and Pseudomonas spp. Egypt. J. Biol. Pest Control. 2023, 33, 106. [Google Scholar]
- Karačić, V.; Miljaković, D.; Marinković, J.; Ignjatov, M.; Milošević, D.; Tamindžić, G.; Ivanović, M. Bacillus Species: Excellent Biocontrol Agents against Tomato Diseases. Microorganisms 2024, 12, 457. [Google Scholar] [CrossRef]
- Rahman, M. Bacillus spp.: A promising biocontrol agent of root, foliar, and postharvest diseases of plants. In Bacilli and Agrobiotechnology; Islam, M.T., Rahman, M., Pandey, P., Jha, C.K., Aeron, A., Eds.; Springer International Publishing: Cham, Switzerland, 2016; pp. 113–141. [Google Scholar]
- Anckaert, A.; Arias, A.A.; Hoff, G. The use of Bacillus spp. as bacterial biocontrol agents to control plant diseases. In Microbial Bioprotectants for Plant Disease Management; Köhl, J., Ravensberg, W., Eds.; Burleigh Dodds Science Publishing: Cambridge, UK, 2022; pp. 1–54. [Google Scholar]
- Nie, L.J.; Ye, W.Q.; Xie, W.Y.; Zhou, W.W. Biofilm: New insights in the biological control of fruits with Bacillus amyloliquefaciens B4. Microbiol. Res. 2022, 265, 127196. [Google Scholar] [CrossRef] [PubMed]
- Kumari, M.; Qureshi, K.A.; Jaremko, M.; White, J.; Singh, S.K.; Sharma, V.K.; Singh, K.K.; Santoyo, G.; Puopolo, G.; Kumar, A. Deciphering the role of endophytic microbiome in postharvest diseases management of fruits: Opportunity areas in commercial up-scale production. Front. Plant Sci. 2022, 13, 4390. [Google Scholar]
- Chávez-Díaz, I.F.; Angoa-Pérez, V.; López-Díaz, S.; Velázquez-del Valle, M.G.; Hernández-Lauzardo, A.N. Antagonistic bacteria with potential for biocontrol on Rhizopus stolonifer obtained from blackberry fruits. Fruits 2014, 69, 41–46. [Google Scholar]
- Chavez-Diaz, I.F.; Mena-Violante, H.G.; Hernandez-Lauzardo, A.N.; Oyoque-Salcedo, G.; Oregel-Zamudio, E.; Angoa-Perez, M.V. Postharvest control of Rhizopus stolonifer on blackberry (Rubus fruticosus) by blackberry native crop bacteria. Rev. Fac. Cienc. 2019, 51, 306–317. [Google Scholar]
- Kilani-Feki, O.; Khedher, S.B.; Dammak, M.; Kamoun, A.; Jabnoun-Khiareddine, H.; Daami-Remadi, M.; Tounsi, S. Improvement of antifungal metabolites production by Bacillus subtilis V26 for biocontrol of tomato postharvest disease. Biol. Control 2016, 95, 73–82. [Google Scholar]
- Gotor-Vila, A.; Teixidó, N.; Di Francesco, A.; Usall, J.; Ugolini, L.; Torres, R.; Mari, M. Antifungal effect of volatile organic compounds produced by Bacillus amyloliquefaciens CPA-8 against fruit pathogen decays of cherry. Food Microb. 2017, 64, 219–225. [Google Scholar]
- Zhang, X.; Gao, Z.; Zhang, X.; Bai, W.; Zhang, L.; Pei, H.; Zhang, Y. Control effects of Bacillus siamensis G-3 volatile compounds on raspberry postharvest diseases caused by Botrytis cinerea and Rhizopus stolonifer. Biol. Control 2020, 141, 104135. [Google Scholar]
- Zeriouh, H.; Romero, D.; García-Gutiérrez, L.; Cazorla, F.M.; Vicente, A.; Perez-Garcia, A. The iturin-like lipopeptides are essential components in the biological control arsenal of Bacillus subtilis against bacterial diseases of cucurbits. Mol. Plant Microbe Interact. 2011, 24, 1540–1552. [Google Scholar]
- Wu, L.; Shang, H.; Gu, H.; Zheng, J. Bacterial iturins mediate biocontrol activity of Bacillus sp. against postharvest pear fruit-rotting fungi. J. Phytopathol. 2019, 167, 501–509. [Google Scholar]
- Cantabella, D.; Dolcet-Sanjuan, R.; Teixidó, N. Using plant growth-promoting microorganisms (PGPMs) to improve plant development under in vitro culture conditions. Planta 2022, 255, 117. [Google Scholar]
- Baldan, E.; Nigris, S.; Romualdi, C.; D’Alessandro, S.; Clocchiatti, A.; Zottini, M.; Stevanato, P.; Squartini, A.; Baldan, B. Beneficial bacteria isolated from grapevine inner tissues shape Arabidopsis thaliana roots. PLoS ONE 2015, 10, e0140252. [Google Scholar] [CrossRef] [PubMed]
- Ryu, C.M.; Hu, C.H.; Locy, R.D.; Kloepper, J.W. Study of mechanisms for plant growth promotion elicited by rhizobacteria in Arabidopsis thaliana. Plant Soil 2005, 268, 285–292. [Google Scholar] [CrossRef]
- Zhang, H.; Kim, M.S.; Krishnamachari, V.; Payton, P.; Sun, Y.; Grimson, M.; Farag, M.A.; Ryu, C.M.; Allen, R.; Melo, I.S.; et al. Rhizobacterial volatile emissions regulate auxin homeostasis and cell expansion in Arabidopsis. Planta 2007, 226, 839–851. [Google Scholar] [CrossRef] [PubMed]
- Pérez-Flores, P.; Valencia-Cantero, E.; Altamirano-Hernández, J.; Pelagio-Flores, R.; López-Bucio, J.; García-Juárez, P.; Macías-Rodríguez, L. Bacillus methylotrophicus M4-96 isolated from maize (Zea mays) rhizoplane increases growth and auxin content in Arabidopsis thaliana via emission of volatiles. Protoplasma 2017, 254, 2201–2213. [Google Scholar] [CrossRef]
- Ivanchenko, M.G.; Napsucialy-Mendivil, S.; Dubrovsky, J.G. Auxin-induced inhibition of lateral root initiation contributes to root system shaping in Arabidopsis thaliana. Plant J. 2010, 64, 740–752. [Google Scholar] [CrossRef]
- Vacheron, J.; Desbrosses, G.; Bouffaud, M.L.; Touraine, B.; Moënne-Loccoz, Y.; Muller, D.; Legendre, L.; Wisniewski-Dyé, F.; Prigent-, C.l. Plant growth-promoting rhizobacteria and root system functioning. Front. Plant Sci. 2013, 4, 356. [Google Scholar] [CrossRef]
- Akram, W.; Sharif, S.; Rehman, A.; Anjum, T.; Ali, B.; Aftab, Z.-e.-H.; Shafqat, A.; Afzal, L.; Munir, B.; Rizwana, H.; et al. Exploring the Potential of Bacillus subtilis IS1 and B. amyloliquificiens IS6 to Manage Salinity Stress and Fusarium Wilt Disease in Tomato Plants by Induced Physiological Responses. Microorganisms 2024, 12, 2092. [Google Scholar] [CrossRef]
- Sunita, K.; Mishra, I.; Mishra, J.; Prakash, J.; Arora, N.K. Secondary metabolites from halotolerant plant growth promoting rhizobacteria for ameliorating salinity stress in plants. Front. Microbiol. 2020, 11, 567768. [Google Scholar] [CrossRef]
- Vaishnav, A.; Shukla, A.K.; Sharma, A.; Kumar, R.; Choudhary, D.K. Endophytic bacteria in plant salt stress tolerance: Current and future prospects. J. Plant Growth Regul. 2019, 38, 650–668. [Google Scholar] [CrossRef]
- Ramasamy, K.P.; Mahawar, L. Coping with salt stress-interaction of halotolerant bacteria in crop plants: A mini review. Front. Microbiol. 2023, 14, 1077561. [Google Scholar] [CrossRef]
- Mishra, P.; Mishra, J.; Arora, N.K. Plant growth promoting bacteria for combating salinity stress in plants–Recent developments and prospects: A review. Microbiol Res. 2021, 252, 126861. [Google Scholar] [CrossRef] [PubMed]
- Bhagat, N.; Raghav, M.; Dubey, S.; Bedi, N. Bacterial exopolysaccharides: Insight into their role in plant abiotic stress tolerance. J. Microbiol. Biotechnol. 2021, 31, 1045. [Google Scholar] [CrossRef] [PubMed]
- Mahmood, A.; Turgay, O.C.; Farooq, M.; Hayat, R. Seed biopriming with plant growth promoting rhizobacteria: A review. FEMS Microbiol. Ecol. 2016, 92, fiw112. [Google Scholar] [CrossRef] [PubMed]
- Lopes, M.J.D.S.; Dias-Filho, M.B.; Gurgel, E.S.C. Successful plant growth-promoting microbes: Inoculation methods and abiotic factors. Front. Sustain. Food Syst. 2021, 5, 606454. [Google Scholar] [CrossRef]
- Tan, S.; Jiang, Y.; Song, S.; Huang, J.; Ling, N.; Xu, Y.; Shen, Q. Two Bacillus amyloliquefaciens strains isolated using the competitive tomato root enrichment method and their effects on suppressing Ralstonia solanacearum and promoting tomato plant growth. Crop Prot. 2013, 43, 134–140. [Google Scholar] [CrossRef]
- Esitken, A.; Yildiz, H.E.; Ercisli, S.; Donmez, M.F.; Turan, M.; Gunes, A. Effects of plant growth promoting bacteria (PGPB) on yield, growth and nutrient contents of organically grown strawberry. Sci. hortic. 2010, 124, 62–66. [Google Scholar] [CrossRef]
- Myresiotis, C.K.; Karaoglanidis, G.S.; Vryzas, Z.; Papadopoulou-Mourkidou, E. Evaluation of plant-growth-promoting rhizobacteria, acibenzolar-S-methyl and hymexazol for integrated control of Fusarium crown and root rot on tomato. Pest Manag. Sci. 2012, 68, 404–411. [Google Scholar] [CrossRef]
- Cabra Cendales, T.; Rodríguez González, C.A.; Villota Cuásquer, C.P.; Tapasco Alzate, O.A.; Hernández Rodríguez, A. Bacillus effect on the germination and growth of tomato seedlings (Solanum lycopersicum L.). Acta Biol. Colomb. 2017, 22, 37–44. [Google Scholar] [CrossRef]
- Cochard, B.; Giroud, B.; Crovadore, J.; Chablais, R.; Arminjon, L.; Lefort, F. Endophytic PGPR from tomato roots: Isolation, in vitro characterization and in vivo evaluation of treated tomatoes (Solanum lycopersicum L.). Microorganisms 2022, 10, 765. [Google Scholar] [CrossRef]

| Pathogens | Radius of Controls (cm) | Radius Inhibited by Amfr20 (cm) | Inhibition (%I) |
|---|---|---|---|
| R. solani | 3.64 ± 0.35 | 1.51 ± 0.18 **** | 58.51 |
| FORL | 3.27 ± 0.42 | 0.87 ± 0.14 **** | 73.39 |
| C. acutatum | 3.76 ± 0.88 | 1.26 ± 0.14 **** | 66.49 |
| V. dahliae | 2.96 ± 0.43 | 1.11 ± 0.07**** | 62.5 |
| Final Concentration (μg/mL) | Antibiotics | |||||
|---|---|---|---|---|---|---|
| Kanamycin (Kan) | Rifampicin (Rif) | Streptomycin (Str) | Tetracyclin (Tet) | Ampicillin (Amp) | Chloramphenicol (Chl) | |
| 10 | S (9 mm) | R | R | R | R | R |
| 30 | S (12 mm) | S (9 mm) | R | R | R | R |
| 50 | S (14 mm) | S (12 mm) | S (8.5 mm) | R | S (9 mm) | R |
| Strain | orthoANI % | dDDH % |
|---|---|---|
| Amfr20 | 100 | 100 |
| B. velezensis strain BIM B-454D CP082262.1 | 98.99 | 91.7 |
| B. velezensis strain FZB42 CP000560.1 | 98.38 | 85.6 |
| B. velezensis strain NST6 CP063687.1 | 98.65 | 88.5 |
| B. velezensis strain GB03 CP049904.1 | 98.38 | 85.6 |
| B. velezensis strain UA2208 CP097586.1 | 98.36 | 85.4 |
| B. velezensis strain NJ13 CP076414.1 | 98.32 | 85.4 |
| B. velezensis strain MBI600 CP094686.1 | 98.33 | 85.4 |
| B. velezensis strain QST713 CP025079.1 | 97.99 | 84.8 |
| B. velezensis strain JS25R CP009679.1 | 99.19 | 93.2 |
| Β. velezensis NRRL B-41580 NZ_LLZC00000000.1 T | 99.37 | 94.90 |
| Region | Size | Most Similar Known Cluster | Synthetase Type | Metabolite | MIBiG ID (% of Genes Show Similarity) |
|---|---|---|---|---|---|
| 1.1 | 50,506 nt | acn | RiPP | Amylocyclicin | BGC0000616 (100%) |
| dhb | NRPS | Bacillibactin | BGC0001185 (100%) | ||
| 1.2 | 68,421 nt | - | NRPS | - | - |
| 1.3 | 41,419 nt | bac | Other | Bacilycin | BGC0001184 (100%) |
| 1.4 | 23,189 nt | mrs | Lanthipeptide | Mersacidin | BGC0000527 (100%) |
| 4.1 | 65,408 nt | srf | NRPS | Surfactin | BGC0000433 (82%) |
| 5.1 | 40,891 nt | - | Phosphonate | - | - |
| 6.1 | 41,245 nt | btr | PKS | Butirosin A | BGC0000693 (7%) |
| 6.2 | 20,741 nt | - | Terpene | - | - |
| 6.3 | 86,374 nt | pksX | transAT-PKS | Macrolactin H | BGC0000181 (100%) |
| 6.4 | 102,629 nt | bae | NRPS, transAT-PKS | Bacillaene | BGC0001089 (100%) |
| 6.5 | 137,509 nt | bmy | NRPS, Polyketide | Βacillomycin D | BGC0001090 (100%) |
| fen | NRPS | Fengycin | BGC0001095 (93%) | ||
| 7.1 | 21,884 nt | - | Terpene | - | - |
| 7.2 | 41,101 nt | - | T3PKS | - | - |
| 7.3 | 93,790 nt | dif | transAT-PKS | Difficidin | BGC0000176 (100%) |
| Families | Activity | Gene Copy Numbers | CAZyme Categories |
|---|---|---|---|
| GH1 | β-glucosidase 4 | 4 | Glycoside Hydrolases (GHs) |
| GH3 | β-glucosidase 1 | 1 | |
| GH4 | maltose-6-phosphate glucosidase 4 | 3 | |
| GH5 | Cellulase | 1 | |
| GH11 | endo-β-1,4-xylanase | 1 | |
| GH13 | α-amylase | 4 | |
| GH16 | Xyloglucan | 1 | |
| GH23 | lysozymetype G | 3 | |
| GH26 | β-mannanase | 1 | |
| GH30 | endo-β-1,4-xylanase | 2 | |
| GH32 | Invertase | 3 | |
| GH43 | β-xylosidase | 4 | |
| GH46 | Chitosanase | 1 | |
| GH51 | Endoglucanase | 2 | |
| GH53 | endo-β-1,4-galactanase | 1 | |
| GH65 | α,α-trehalase | 1 | |
| GH68 | Levansucrase | 1 | |
| GH73 | Lysozyme | 3 | |
| GH109 | α-N-acetylgalactosaminidase | 1 | |
| GH126 | α-amylase | 1 | |
| GH171 | peptidoglycan β-N-acetylmuramidase | 1 | |
| GT1 | UDP-glucuronosyltransferase | 3 | Glycosyl Transferases (GTs) |
| GT2 | Cellulosesynthase | 16 | |
| GT4 | Sucrosesynthase | 8 | |
| GT8 | lipopolysaccharide α-1,3-galactosyltransferase | 1 | |
| GT26 | UDP-ManNAcA: β-N-acetyl mannosaminuronyltransferase | 1 | |
| GT28 | 1,2-diacylglycerol 3-β-galactosyltransferase | 2 | |
| GT51 | Mureinpolymerase | 4 | |
| GT83 | undecaprenyl phosphate-α-L-Ara4N: 4-amino-4-deoxy-β-L-arabinosyltransferase | 2 | |
| CE4 | Acetylxylanesterase | 7 | Polysaccharide Esterases (CEs) |
| CE6 | Acetylxylanesterase | 1 | |
| CE7 | Acetylxylanesterase | 1 | |
| CE9 | N-acetylglucosamine 6-phosphate deacetylase | 1 | |
| CE14 | N-acetyl-1-D-myo-inosityl-2-amino-2-deoxy-α-D-glucopyranoside deacetylase | 2 | |
| PL1 | Pectatelyase | 2 | Lyases (PLs) |
| PL9 | Pectatelyase | 1 | |
| AA4 | vanillyl-alcoholoxidase | 1 | Growth factors (AAs) |
| AA6 | 1,4-benzoquinone reductase | 1 | |
| AA7 | Glucooligosaccharideoxidase | 2 | |
| AA10 | Lyticpolysaccharidemonooxygenases | 1 | |
| CBM6 | Binding proteins (GH18, GH19, GH23, GH24, GH25 and GH73) in carbohydrates like cellulose and glucomannan (CBMs) | 1 | Carbohydrate-binding proteins (CBMs) |
| CBM26 | 1 | ||
| CBM34 | 1 | ||
| CBM50 | 10 |
Disclaimer/Publisher’s Note: The statements, opinions and data contained in all publications are solely those of the individual author(s) and contributor(s) and not of MDPI and/or the editor(s). MDPI and/or the editor(s) disclaim responsibility for any injury to people or property resulting from any ideas, methods, instructions or products referred to in the content. |
© 2025 by the authors. Licensee MDPI, Basel, Switzerland. This article is an open access article distributed under the terms and conditions of the Creative Commons Attribution (CC BY) license (https://creativecommons.org/licenses/by/4.0/).
Share and Cite
Spantidos, T.-N.; Douka, D.; Katinakis, P.; Venieraki, A. Genomic Insights into Plant Growth Promotion and Biocontrol of Bacillus velezensis Amfr20, an Olive Tree Endophyte. Horticulturae 2025, 11, 384. https://doi.org/10.3390/horticulturae11040384
Spantidos T-N, Douka D, Katinakis P, Venieraki A. Genomic Insights into Plant Growth Promotion and Biocontrol of Bacillus velezensis Amfr20, an Olive Tree Endophyte. Horticulturae. 2025; 11(4):384. https://doi.org/10.3390/horticulturae11040384
Chicago/Turabian StyleSpantidos, Tasos-Nektarios, Dimitra Douka, Panagiotis Katinakis, and Anastasia Venieraki. 2025. "Genomic Insights into Plant Growth Promotion and Biocontrol of Bacillus velezensis Amfr20, an Olive Tree Endophyte" Horticulturae 11, no. 4: 384. https://doi.org/10.3390/horticulturae11040384
APA StyleSpantidos, T.-N., Douka, D., Katinakis, P., & Venieraki, A. (2025). Genomic Insights into Plant Growth Promotion and Biocontrol of Bacillus velezensis Amfr20, an Olive Tree Endophyte. Horticulturae, 11(4), 384. https://doi.org/10.3390/horticulturae11040384

